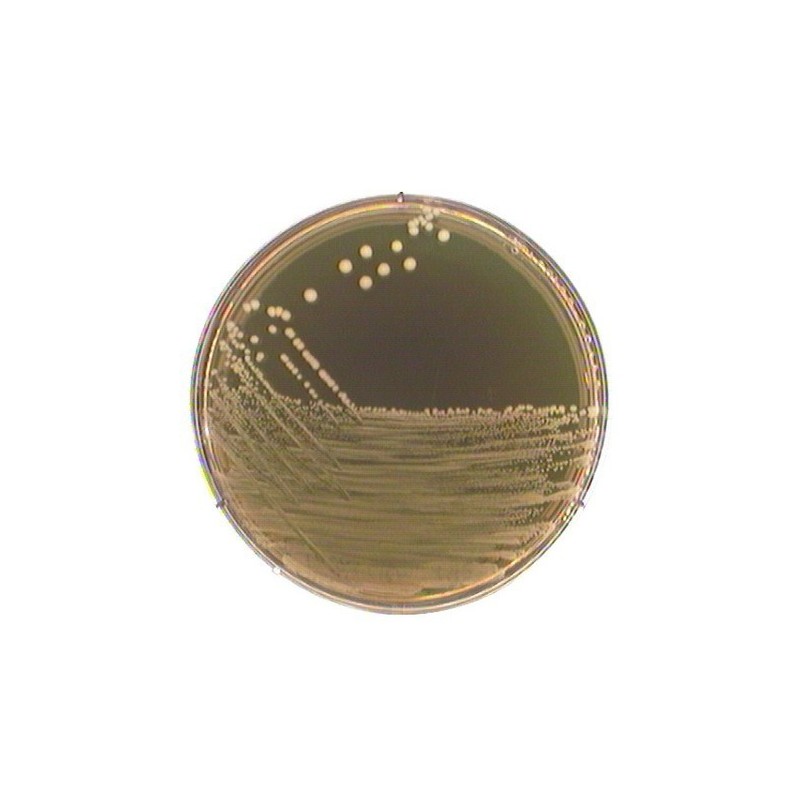
Агар М 17 асс. TERZAGHI, 500гр

М 17 агар асс. TERZAGHI для микробиологии 500гр 1.15108.0500
Среды предложены Terzaghi и Sandine для культивирования и учета молочнокислых стрептококков в молоке и молочных продуктах и дифференциации бактериофагов, инфицирующих стрептококки.
Состав (г / л)
Пептон из соевой муки - 5.0;
пептон из мяса - 2,5;
пептон из казеина - 2,5;
дрожжевой экстракт - 2,5,
экстракт мяса - 5,0;
моногидрат лактозы - 5,0;
аскорбиновая кислота - 0,5;
натрий-б-глицерофосфат - 19,0;
сульфат магния - 0,25;
агар-агар - 12,75.
Среда М-17 лучше других подходит для культивирования требовательных к условиям роста видов Str. cremoris, Str. diacetilactis, Str. lactis. Мутанты, неспособные к утилизации лактозы, также могут быть выделены на этих средах.
Хранить при температуре от + 15 °C до + 25 °C.
Не удаётся отправить вашу оценку отзыва
Пожаловаться на комментарий
Жалоба отправлена
Не удаётся отправить вашу жалобу
Оставьте свой отзыв
Отзыв отправлен
Не удаётся отправить отзыв
М 17 агар асс. TERZAGHI для микробиологии 500гр 1.15108.0500
check_circle
check_circle














